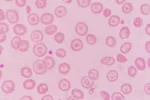
Talasemia, cómo abordar los problemas con los glóbulos rojos Talasemia

Tratamiento de la talasemia

Las transfusiones de sangre son una de las opciones terapéuticas existentes en algunas formas de talasemia.
Especialista en Medicina Interna del Hospital Universitario Príncipe de Asturias
Actualizado: 28 de junio de 2022
En algunos casos la talasemia puede no provocar síntomas y no requerir tratamiento, mientras que en otros sí muestran síntomas y requieren ser abordados. Las diferentes opciones de las que se dispone actualmente para tratar las talasemias son las siguientes:

Pronóstico de la talasemia
El pronóstico de las talasemias es muy variable, de tal forma que mientras algunas de ellas no producen síntomas y solo se diagnostican si se realizan estudios familiares, otras producen una afectación tan severa que son incompatibles con la vida, produciendo la muerte de los pacientes afectados.
Hay que tener en cuenta también posibles complicaciones que pueden aparecer en pacientes con talasemia y que empeoran el pronóstico, por ejemplo, aquellas personas que reciben transfusiones de sangre muy frecuentemente pueden acumular una gran cantidad de hierro en el organismo, lo que puede afectar gravemente a órganos como el hígado. Para ello existen remedios terapéuticos como los quelantes.
El consejo genético y la evaluación prenatal pueden ayudar a las personas con antecedentes familiares de esta enfermedad a tomar decisiones cuando se planteen tener hijos.
Creado: 22 de agosto de 2014